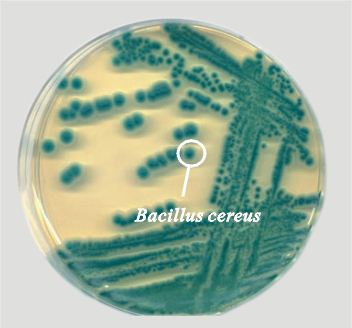
蜡状芽孢杆菌

万千商家帮你免费找货
0 人在求购买到急需产品
- 详细信息
- 技术资料
- 生长状态:
冻干管,斜面培养物
- 运输方式:
冻干管,斜面培养物
- 供应商:
北纳生物
- 英文名:
Bacillus cereus
BNCC338099 蜡状芽孢杆菌
| 基本信息 | |
| 资源编号 | BNCC338099 |
| 其它编号 | =ATCC 14579 =BCRC 10603 =DSM 31 =NBRC 15305 =NCTC 2599 =NRRL B-3711 |
| 资源名称 | 蜡状芽孢杆菌 |
| 种属 | Bacillus cereus |
| 提供形式 | 冻干管,斜面培养物 |
| 安全等级 | 2 |
| 模式菌株 | 未知 |
| 应用领域 | 模式菌株 |
| 说明书 | 点击下载 |
| 培养方法 | |
| 培养基 | 营养肉汁琼脂:牛肉膏 3.0g,蛋白胨 10.0g,NaCl 5.0g,琼脂 15.0g,蒸馏水 1.0L,pH7.0。[注] 培养芽孢杆菌时加入5mg MnSO4·H2O,则有利于产生芽孢。pH7.0。121℃,15min。 |
| 传代方法 | ①冻干管:75%酒精擦拭管壁,后用砂轮在冻干管壁划两圈,掰断,用200μL无菌水或培养基充分溶解,平板涂布,活化培养。 ②斜面:试管口用75%酒精擦拭后,火焰灼烧,后用无菌接种铲切块,挑取接入平板或斜面,培养。 |
| 生长条件 | 30℃,好氧 |
| 生长特性 | 革兰氏阳性细菌,形成芽孢。 |
| 存储条件 | 2-8℃冷藏 |
风险提示:丁香通仅作为第三方平台,为商家信息发布提供平台空间。用户咨询产品时请注意保护个人信息及财产安全,合理判断,谨慎选购商品,商家和用户对交易行为负责。对于医疗器械类产品,请先查证核实企业经营资质和医疗器械产品注册证情况。
技术资料暂无技术资料 索取技术资料
蜡状芽孢杆菌
询价